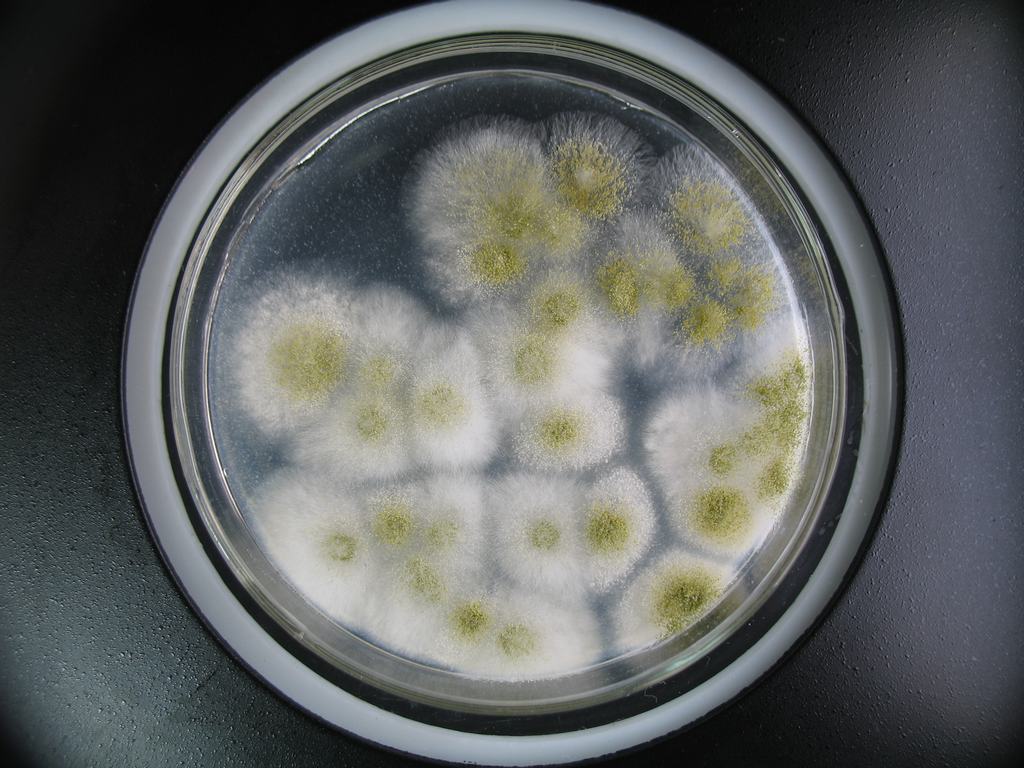
黄色毛霉

毛霉形态
黄色毛霉
图片尺寸1024x768
毛霉目
图片尺寸1080x2287
毛霉目
图片尺寸1080x2287
毛霉目
图片尺寸2667x2000
好好好,又离成功远了一步#毛霉#发疯日常 #实验 #米曲霉 - 抖音
图片尺寸1440x1920
毛霉目
图片尺寸2000x2667
毛霉摄影图
图片尺寸450x300
毛霉目
图片尺寸1080x2287
【资源】毛霉科真菌
图片尺寸448x374
毛霉目
图片尺寸2000x2667
毛霉的介绍
图片尺寸268x378
毛霉的生长需要哪些条件?
图片尺寸600x380毛霉属
图片尺寸412x581
毛霉菌
图片尺寸492x300
毛霉
图片尺寸578x568
真菌形色covid19相关的毛霉病及实验室检测
图片尺寸1303x830
毛霉菌(mucor)又叫黑霉,长毛霉.
图片尺寸300x240长卧黑莓上的霉菌-霉菌霉菌.
图片尺寸1200x800
面包毛霉扫描电镜图
图片尺寸1024x704
毛霉是一种丝状真菌,分布广泛,常见于土壤,水果,豆腐等上,具有发达
图片尺寸668x927